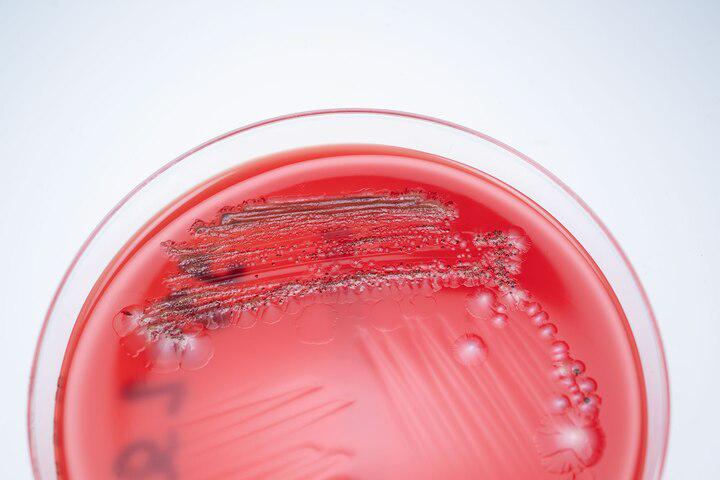

每天更新,最新的趋势和见解,助您提升英语阅读水平。

为什么世界上两位顶尖攀岩者决定让他们的攀登变得更加艰难

Why two of the world's best rock climbers decided to make their climb much, much harder
为什么世界上两位顶尖攀岩者决定让他们的攀登变得更加艰难
2026-01-28
2231词 晦涩

北美野生鹤的惊险5000英里飞行

The harrowing 5,000-mile flight of North America's wild whooping cranes
北美野生鹤的惊险5000英里飞行
2026-01-28
3116词 晦涩

一场玻璃革命正在进行中。剧透:它可以弯曲并反弹

A glass revolution is underway. Spoiler alert: it bends and bounces
一场玻璃革命正在进行中。剧透:它可以弯曲并反弹
2026-01-28
2557词 晦涩

赫梯帝国改变了世界——然后世界遗忘了它

The Hittite Empire transformed the world—and then the world forgot it
赫梯帝国改变了世界——然后世界遗忘了它
2026-01-28
3068词 晦涩

邮轮旅行正在改变——2026年的最大趋势解析

Cruise travel is changing—here are the biggest trends for 2026
邮轮旅行正在改变——2026年的最大趋势解析
2026-01-22
2312词 晦涩

深海钢球内,这些探险者创造了历史

Inside a steel sphere deep underwater, these explorers made history
深海钢球内,这些探险者创造了历史
2026-01-16
6559词 晦涩

认识那些试图拯救天堂的加拉帕戈斯人

Meet the Galapagueños who are trying to save paradise
认识那些试图拯救天堂的加拉帕戈斯人
2026-01-16
2099词 晦涩

类固醇的使用比大多数人想象的更普遍

Steroid use is more widespread than most people believe
类固醇的使用比大多数人想象的更普遍
2026-01-15
3431词 晦涩

自称玛丽·安托瓦内特之子的神秘男子

The mystery man who claimed to be Marie-Antoinette’s son
自称玛丽·安托瓦内特之子的神秘男子
2026-01-06
2362词 晦涩

自然灾害后智慧城市的重塑

How smart cities are being reinvented after natural disasters
自然灾害后智慧城市的重塑
2026-01-06
4434词 晦涩

大冒险,小船只——2026年26个最佳航程推荐

Big adventures, small ships—26 of the best voyages to book for 2026
大冒险,小船只——2026年26个最佳航程推荐
2026-01-06
2466词 晦涩

经期疼痛长期被忽视,这一情况正在改变

Period pain has long been ignored. That’s changing.
经期疼痛长期被忽视,这一情况正在改变
2026-01-06
2095词 晦涩

伦敦最美丽独特的私人会员俱乐部内部揭秘

Inside London's most beautiful and unique private members' clubs
伦敦最美丽独特的私人会员俱乐部内部揭秘
2025-12-25
2391词 困难

在瑞典拉普兰公路旅行中探索萨米手工艺

Explore Sámi crafts on a road trip through Swedish Lapland
在瑞典拉普兰公路旅行中探索萨米手工艺
2025-12-25
2855词 晦涩

北波兰正在经历一场烹饪复兴——这里是原因所在

A culinary revival is taking place in northern Poland—here's why
北波兰正在经历一场烹饪复兴——这里是原因所在
2025-12-24
2084词 晦涩

全球寻找揭示… 粪便治愈力量的秘诀
The global hunt to unlock the healing powers of … poop
全球寻找揭示… 粪便治愈力量的秘诀
2025-12-17
3785词 晦涩

过去25年的最大科学突破

The biggest scientific breakthroughs of the last 25 years
过去25年的最大科学突破
2025-12-15
3933词 晦涩

约柜发生了什么?这是我们所知道的

What happened to the Ark of the Covenant? Here’s what we know.
约柜发生了什么?这是我们所知道的
2025-12-13
2229词 晦涩
与保护乌干达大猩猩的人一起追踪大猩猩
Track gorillas in Uganda with the people who protect them
与保护乌干达大猩猩的人一起追踪大猩猩
2025-12-13
2263词 晦涩

改变非洲大象命运的男人
